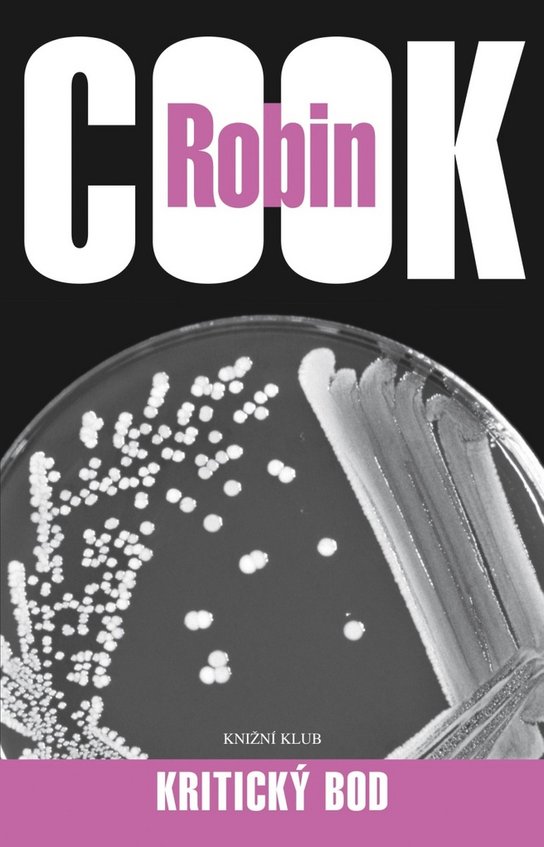
Kritický bod

Povedačky
Výrobce: Vydavateľstvo BUVIK, s. r. o.
EAN: 9788081240652
Tanulinky, tanky, drž sa, otec, Hanky, Hop, hop na koníčku, Nes ma, slimák, nes a iné rytmické a hravé povedačky, ale i obľúbené veršované rozprávky na memorovanie ako Zatúlané húsa, Môj Macík, Ranená breza, tvoria výber z diela vynikajúcej klasičky detskej literatúry.
Cena 146 Kč v 1 obchodě
Zobrazit historii ceny Povedačky
Historie nejnižsí ceny Povedačky. Porovnání obchodů, které prodávají Povedačky.